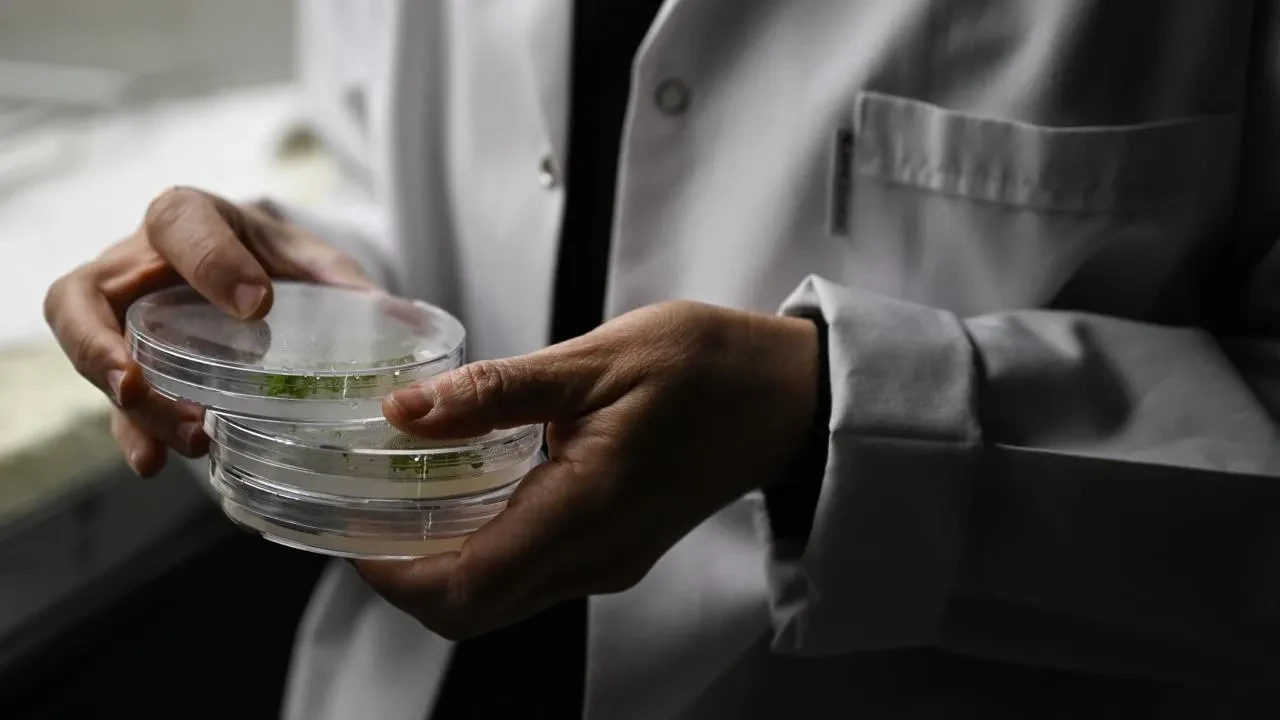
Ömrü yüzde 35 uzatan kokteyli keşfettiler! Farelerde olumlu sonuç verdi sıra insanlarda

Kategoriler
UYGULAMALAR
İstanbul

İki kanser ilacını bir araya getiren Avrupalı bilim insanları fareler üzerinde ömrü uzatan geri dönüşler elde etti.
Araştırmada iki farklı ilaç test edildi:
Rapamisin: Organ nakillerinde bağışıklık tepkisini baskılamak için kullanılan, aynı zamanda daha önce hayvanlarda yaşam süresini uzattığı bilinen bir ilaç.
Trametinib: Bazı kanser türlerinde kullanılan ve meyve sineklerinde yaşam süresini artırdığı kanıtlanmış başka bir ilaç.
Bu ilaçlar farelere hem tek başlarına hem de birlikte verildi. Sonuçlar oldukça dikkat çekici:

İlaç kokteyliyle tedavi edilen farelerde yalnızca ömür değil, yaşlılıkla bağlantılı birçok hastalık da ertelendi:
Dişi farelerde ortalama yaşam süresi yüzde 34,9, erkeklerde ise yüzde 27,4 oranında arttı. Maksimum yaşam süresi ise sırasıyla yüzde 32,4 ve yüzde 26,1 oranında uzadı.

Araştırmaya göre her iki ilaç da yaşlanma sürecinde rol oynayan Ras/İnsülin/TOR sinyal yolunu hedef alıyor.
Ancak farklı noktalara etki ettikleri için birlikte kullanıldıklarında etkileri güçleniyor.
Önemli bir detay ise şu: Herhangi bir yan etki gözlenmedi. Bu da kombinasyonun güvenli olabileceğine dair umut verici bir veri sunuyor.

Araştırmanın başyazarı Prof. Linda Partridge, bu sonuçların insanlar için doğrudan geçerli olmayabileceğini ancak yaşlılık döneminde sağlıklı kalma süresinin uzatılması açısından büyük potansiyel taşıdığını vurguladı.

Her iki ilaç da hâlihazırda ABD ve Avrupa’da insanlar için onaylı olduğu için, insanlarda yaşlanmayı yavaşlatma hedefiyle klinik deneylerin kısa sürede başlayabileceği belirtiliyor.
Nitekim, rapamisin daha önce perimenopoz dönemindeki kadınlarda doğurganlık süresini 5 yıla kadar uzattığı bir başka çalışmada da öne çıkmıştı.

Nature Aging dergisinde yayımlanan bu araştırma, yaşlanmanın biyolojik olarak nasıl kontrol altına alınabileceğine dair önemli bir adım olarak değerlendiriliyor. Gelecekte, sağlıklı yaş alma sürecinin bir "tercih" haline gelmesi mümkün olabilir.